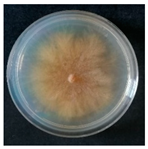
Forests 14 02029 i003
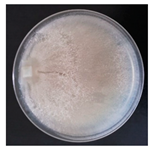
Forests 14 02029 i004
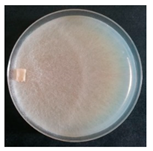
Forests 14 02029 i005
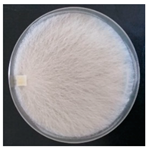
Forests 14 02029 i007
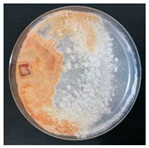
Forests 14 02029 i008
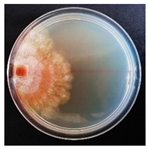
Forests 14 02029 i009
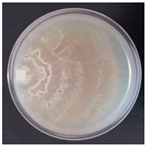
Forests 14 02029 i010
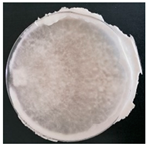
Forests 14 02029 i011
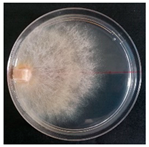
Forests 14 02029 i012
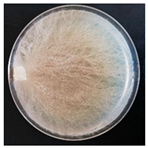
Forests 14 02029 i013
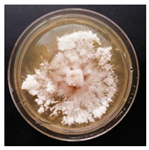
Forests 14 02029 i017
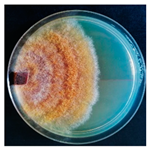
Forests 14 02029 i018
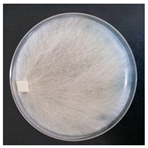
Forests 14 02029 i020
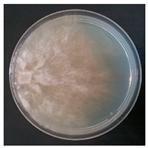
Forests 14 02029 i022
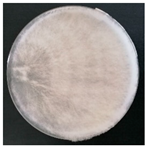
Forests 14 02029 i023
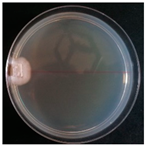
Forests 14 02029 i024
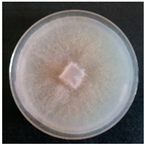
Forests 14 02029 i025
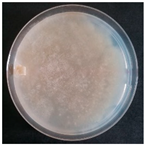
Forests 14 02029 i026
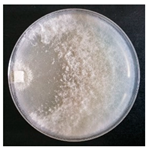
Forests 14 02029 i030
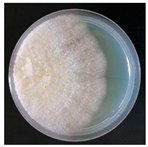
Forests 14 02029 i033
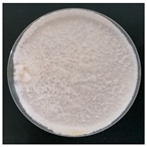
Forests 14 02029 i034
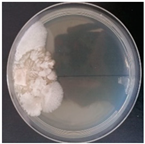
Forests 14 02029 i036
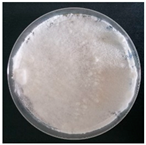
Forests 14 02029 i037
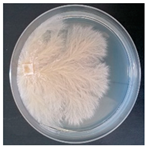
Forests 14 02029 i038
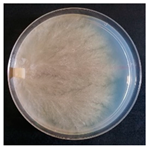
Forests 14 02029 i039
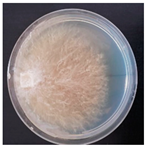
Forests 14 02029 i041
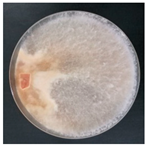
Forests 14 02029 i043
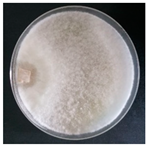
Forests 14 02029 i044
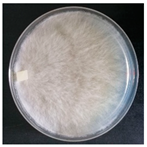
Forests 14 02029 i048
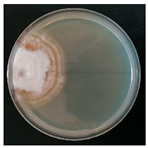
Forests 14 02029 i049
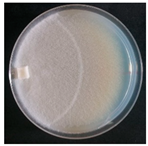
Forests 14 02029 i050
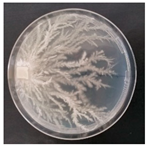
Forests 14 02029 i051
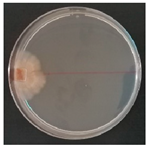
Forests 14 02029 i053
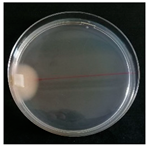
Forests 14 02029 i054
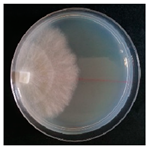
Forests 14 02029 i055
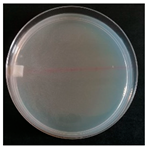
Forests 14 02029 i056

Abstract
Over the last decade, fungal conservation has become an increasingly important topic, especially for species tied to forest ecosystems. Among these, wood decay fungi are a group of interesting species from ecological and applicative points of view. Culture collections represent an important tool for the conservation of species and research material. The aim of this study was to establish the first research culture collection of wood decay fungal strains, mainly corticioid and polyporoid species, at Salamanca University (Spain). From two areas of the Iberian Peninsula, a total of 120 basidiomata were collected and morphologically identified. From these, 55 strains were successfully isolated in pure culture and their identity was confirmed by DNA molecular analysis. The average growth rate of each strain was recorded and mycelium characteristics, such as colony morphology and microscopic features, were described. Notable strains in the collection included: (1) Botryobasidium asperulum and Phlebia rufa for taxonomical studies; (2) Hericium erinaceus, Grifola frondosa and Pleurotus species for medicinal properties; (3) Irpex lacteus, Phanerochaete sordida and Trametes versicolor for their degradation capabilities; (4) Stereum gausapatum and Stereum hirsutum for their applicative and enzymatic potential. The new fungal strain culture collection represents a valuable tool for the ex situ conservation of Mediterranean wood decay fungi.
1. Introduction
Biodiversity conservation has emerged as a driving field in biology and environmental sciences; as a major reference for both scientists and institutions, the IUCN (International Union for the Conservation of Nature) has expanded its Red Lists to include an increasingly diverse range of organisms in order to address the global biodiversity crisis. Today, the IUCN estimates that “more than 42,100 species are threatened with extinction, that is still 28% of all assessed species” [1]. Fungi have one of the greatest ranges of biodiversity on Earth, with 2.2 to 3.8 million species, many of which have yet to be identified and described [2]. Nonetheless, fungal conservation has only recently been consolidated as a topic to address environmental policies, such as through the Global Fungal Red List Initiative (GFRLI) [3]. Everyone can register with the GRFLI in order to propose species for assessment: all the available data on the nominated species are included in a frame based on IUCN protocols and data can be edited and commented on while under assessment; assessment is also subjected to external review and then checked for approval by the chairs of IUCN fungal specialist groups; the final step is the inclusion decision by the IUCN Red List Unit.
Just like other life forms, several fungal species are experiencing threats caused by pollution, climate change, fragmentation and loss of habitats, loss of symbionts, over exploitation and habitat conversion [4]. Despite the fact that the great majority of fungal species has yet to be assessed, 73% out of the 597 fungal species currently on the global red list are found in forest ecosystems [5].
Fungal diversity in forests has different functions and trophic niches, including mycorrhizals, litter saprotrophs, lichenized fungi, etc. Wood decay fungi (WDF) have a major role since they break down the wood components and boost the nutrients cycle [6,7,8].
WDF are a broadly defined group of taxa able to effectively colonise and degrade different lignocellulosic substrates [9,10]. They are present at various stages of wood decay and include both pure (non-pathogenic) saprotrophs and opportunistic pathogens. Depending on the species (both fungal and host) and environmental conditions, the latter cause varying severity of damage to hardwood and sapwood. Such plasticity and variability in degradation, as well as their ecological role, make WDF an optimal research topic in forestry for monitoring the possible shifts in the environmental drivers that cause fungal proliferation and plant decline [11,12]. Furthermore, WDF are extensively studied in industrial biotechnology [13] for applications encompassing medicine and nutraceutics to biomaterials, bioremediation and the degradation of persistent organic pollutants [14,15,16].
As a result of the loss or anthropic change of forest habitats, fungal diversity is an ecological and biotechnological resource that is under increasing threat. The ex situ conservation of fungal strains is thus critical for ensuring the availability of basic and applied research material. WFCC (World Federation for Culture Collections); WFCC-certified culture collections play an important role in this regard [17], as well as research centres and universities research collections, private individuals and companies who respectively collect strains for amateur or industrial purposes [18,19]. Since 1980, the WFCC has provided standards for culture collections in order to establish a global network of collections for ex situ conservation [20]. Therefore, culture collections are essential for collecting, characterising and studying fungal species, archiving their information and conserving strains for basic and applied research, as well as for industrial exploitation. Finally, collections are intrinsically representative of fungal diversity and species richness at various spatial scales (regional, national, etc.) [21]. The overall amount of private and institutional culture collections containing fungal strains around the world is unknown; WFCC has 104 partners broadly referring to “microbes” in general, not only fungi. Analogously, the MIRRI (Microbial Resource Research Infrastructure) “brings together 50+ microbial domain Biological Resource Centres (mBRCs), culture collections and research institutes from ten European countries” [22] but official partners in turn collect data from further collections owned by sub-partners. Several private companies also hold private collections, which are normally protected by industrial secrecy.
The periodical culture check is a major task in any culture collection in order to ascertain the vitality of the cultures themselves, update the nomenclature and check for changes in morphology or conflicts with previous identification. Culture checks are carried out by two methods: morphology and DNA sequencing. DNA sequencing is costly, but it ensures the culture is properly identified. Morphological identifications can be time-consuming but they are required to correctly identify specific cultures, especially if there is no conspecific reference in the DNA sequence database [23].
The Mycology Section in the Department of Botany and Plant Physiology of Salamanca University (Spain) owns a large collection of WDF exsiccata (SALA-Fungi). On the other hand, the Laboratory of Mycology in the Department of Earth and Environmental Sciences of Pavia University (Italy) has a wide research culture collection of WDF strains [24,25]. The aim of this work was to establish a new fungal research culture collection of WDF strains for the ex situ conservation of forest biodiversity in two areas of central and northern Spain. Culture morphology (including a macro- and micromorphological description) and molecular barcoding were used to identify fungal strains. Furthermore, for each strain, a brief overview of its application potential based on literature data has been included. The work also includes basic guidelines for isolating corticioid fungi, which are difficult to isolate in pure culture due to their thin, resupinate context. The current study is the first step towards connecting the new collection to the collection network, which will increase the resources available for fungus conservation.
2. Materials and Methods
WDF strains are obtained by isolating mycelium in pure culture from sporophores collected in the wild (or cultivated). Only fungi from the phylum Basidiomycota (whose sporophores are known as basidiomata) were considered in this study. Thus, the initial step was to collect and identify basidiomata in forests.
2.1. Basidiomata Sampling
Basidiomata sampling was carried out between October and December 2022 in two areas of Spain (Figure 1): (1) 2.67 km2 in Salamanca province, Castilla y León region (Mediterranean zone in the center of Spain); (2) 10.705 km2 in Cantabria region (temperate oceanic climate zone in the north of the Iberian Peninsula) [26].
Figure 1.
Sampling areas: (1) Salamanca province in Castilla y León region (blue); (2) Cantabria region (red). The dotted line within the Castilla y León region represents the borders of Salamanca province. Sampling sites are marked by stars. Source: Google Satellite and Open Street Map re-elaborated by the authors in QGIS 3.10.14.
All the samples were geolocalized by a smartphone (P30 lite, Huawei, Shenzen, China) GPS (Google Maps, Google, Mountain View, CA USA, based on cartographic data 2023 by the Instituto Geográfico Nacional, Madrid, Spain); basic information about the host plant and environmental features was recorded.
Basidiomata were completely or partially harvested using a knife and, in the case of some corticioid species, part of the woody substrate was drawn as well. The samples were then placed in paper packets and isolated in pure culture the same day or stored at 4 °C until processing. Basidiomata that were not used for isolation were dried at 40 °C before being packed and stored in dry conditions. All the exsiccata are currently deposited in SALA-Fungi herbarium under the acronym of the collector Sergio Pérez Gorjón (SPG).
2.2. Strain Isolation in Pure Culture
The isolation of mycelium in pure culture was performed by two different standard methods (slightly modified by the authors) depending on the specimen morphology [27,28].
For specimens with bulky or thick basidiomata, isolation was carried out from the context, i.e., the internal hyphal mass lying between the upper surface and the hymenial layer [29]. Little portions (typically 10 mm3) of context were drawn and inoculated in Petri dishes with 2% malt extract agar (MEA) (Biokar Diagnostics, Allonne, France and VWR Chemicals, Milano, Italy) and 50 ppm chloramphenicol (VWR Chemicals, Milano, Italy) under sterile conditions, e.g., in a biological hood or in close proximity to a flame.
For specimens with thin or very small basidiomata, isolation was carried out from spores. Two methods were used to obtain spores. The first method involved hanging a piece of basidiomata or a piece of wood colonised by the fungus onto a microscope slide with the hymenial surface pointing downward. Wet clothing was draped over the experimental apparatus to generate a humid environment conducive to spore release. Released spores fallen onto the microscope slide were subsequently drawn by an inoculating loop. The inoculating loop was pre-soaked in sterile water to increase spore adhesion. The spores were finally spread out in Petri dishes with 2% MEA + chloramphenicol.
Analogously, the second method consisted of: (1) cutting a little square (usually <1 cm2) piece of the hymenial layer or a gill from the specimen; (2) attaching it on the inside of the top of a Petri dish using vaseline (VWR Chemicals, Milano, Italy) as described and depicted in Choi et al. [30]; (3) incubating the Petri dish in an almost vertical position to allow spores to drop and spread all over the medium surface (this step usually takes 1–2 days).
Petri dishes were incubated at 25 °C in the dark (Biolog, Fratelli Galli, Fizzonasco, Italy) to allow mycelium growth or spore germination. The transplantation of colonies in new 2% MEA Petri dishes was performed as soon as germination was observed (usually by 1 week, depending on the species), whereas colonies grown from context pieces were allowed to colonize the whole dish.
Successfully isolated strains are currently conserved at 4 °C in the SALA-DNA Plant Biobank of the University of Salamanca (Spain) and at 4 °C and −80 °C in the MicUNIPV Research Culture Collection of the University of Pavia (Italy). The cryopreservation procedure at −80 °C is described in Cartabia et al. [24].
Each strain has been assigned the same code number as its related specimen, along with the field data that goes with it.
2.3. Fungal Strain Morphological and Molecular Identification
Collected basidiomata were identified by micro- and macro-morphological features observed with an optical microscope (Leica DM750, Leica Microsystems, Wetzlar, Germany) and a stereomicroscope (LeicaEZ4, Leica Microsystems, Wetzlar, Germany) and through manuals and identification keys [29,31,32].
The morphological identification of isolated strains was further confirmed by molecular analysis (ITS region). Each strain was grown in a 100-mL flask containing 50 mL of 2% malt extract (ME, Biokar diagnostics, Allonne, France) solution and incubated at 25 °C in the dark (thermostat as above) until mycelial biomass was obtained. Biomass was sterilely drawn by tweezers and placed in 1.5-mL Eppendorf tubes for molecular identification; about 20 mg of dry biomass/sample was used for DNA extraction. DNA extraction was performed using a Nucleospin Plant II kit (Macherey-Nagel, Düren, Germany) following the manufacturer’s instructions. DNA concentration was quantified using a NanoDropTM 2000 (Thermo Fisher Scientific, Waltham, MA, USA) and subsequently adjusted to 25 ng/μL prior to PCR. Amplification of the ITS region was carried out using a DreamTaq Green PCR Master Mix (Thermo Fisher Scientific) and ITS1-ITS4 primers (Thermo Fisher Scientific). The complete PCR and purification protocol is described in Girometta et al. [25]. Purified samples were sequenced by Macrogen (Milano, Italy). DNA sequences were edited using Sequencher 5.0 and compared with those available in the GenBank [33] and MycoBank [34] databases.
2.4. Growth Tests and Description of the Fungal Strains
For each fungal strain, three 90-mm Petri dishes (2% MEA) were prepared; agar plugs with actively growing mycelium (surface of about 0.25 cm2) were inoculated at the edge of the Petri dish to allow the fungal colony to expand across the entire diameter of the plate. This also enabled us to track its growth for longer periods of time, up to the entire plate coverage or 6 weeks (arbitrary deadline). Petri dishes were incubated at 25 °C in the dark. Mycelium growth was recorded daily with a calliper (0.1 mm resolution) as the distance between the inoculation point and the edge of the colony, measured over the diameter of the Petri dish. The growth rate was calculated as the average daily growth (mm/day) of the three replicates.
The colony macro-morphology (colour, mycelium aspect) and microscopical characters (such as hyphal morphology, hyphal diameter and peculiar structures) of isolated strains were described. Samples were observed in lacto-fuchsin using a Zeiss Stemi 2000-C (Zeiss, Oberkochen, Germany) stereomicroscope and a Nikon LABOPHOT-2 (Nikon, Minato, Tokyo, Japan) microscope. Descriptions are reported as a set of code numbers corresponding to defined characters (Table 1), adopting a comparable and simplified coding scheme as Nobles [35] and Stalpers [36].
Table 1.
Code numbers and corresponding description of macroscopical and microscopical characters.
3. Results and Discussion
3.1. Basidiomata Sampling, Strains Isolation and Identification
The aim of the wood decay fungal sampling field activity was to collect basidiomata from as many species as possible in order to isolate them in pure culture and obtain a large number of strains. The sample was carried out in natural and semi-natural settings that were abundant in dead wood and WDF species.
The first sampling area location was in Salamanca province (Castilla y León), which has a Mediterranean climate and a high concentration of Pyrenean oak woods, pine forests and holm oak forests. The most frequent host species in this area are Quercus pyrenaica Willd. and Pinus sylvestris L.
The first sampling area location was in the Saja-Besaya Natural Park (Cantabria) and in the Parque Natural Montaña Palentina (Castilla y León, Palencia province), which has a Eurosiberian oceanic climate and is characterized by beech forests and pine forests (generally distinct from each other). The most frequent host species in this area are Fagus sylvatica L., Quercus pyrenaica and Corylus avellana L.
Consistent with the above, climate data indicated different conditions in the two examined areas over the sampling period. Namely, Castilla y Léon recorded 13.5–7.4–4.7 °C vs. 14.4–9.8–7.7 °C in Cantabria as average temperatures in October–November–December, respectively. Analogously, rainfall recorded 65–56–50 mm vs. 119–148–111 mm distributed in 7–7–6 vs. 11–12–11 rainy days. As a whole, the relative humidity was 66–79–82 % vs. 76–79–78% [26].
In the two areas, 120 basidiomata from 90 different species were collected.
Mycelium isolation in pure culture was tried on all acquired samples, either directly from basidiomata or spores. The isolation of 55 strains from 50 different species was achieved (Table 2). On all isolated strains, ITS-based genetic barcoding was performed and results were compared to the morphological identification of the basidiomata. Table 2 lists the accession numbers for all ITS sequences that have been deposited in GenBank. Some species were unable to be isolated due to basidiomata conditions, such as a lack of spore production or deterioration.
Table 2.
Isolated strains currently present in the new culture collection. Code number of the collection, topographic data, number of isolated strains and GenBank accession numbers are reported.
According to the accepted differentiation between “corticioid” versus “polyporoid” species in the literature [29,31], twenty-six out of the fifty isolated species are corticioid, twenty-one are polyporoid and three are agaricoid. The corticioid group has a higher representation than the polyporoid group because the former are more numerous at the sampling sites. The only WDF agaricoid species sampled in this study were Pleurotus eryngii var. ferulae, Pleurotus pulmonarius and Schizophyllum commune.
Isolated strains belonging to nine distinct Orders; Polyporales (50%), Russulales (15%), Agaricales (13%) and Hymenochaetales (9%) have the highest proportion (Figure 2). At the family level, collected specimens are much more differentiated and record 25 different families, with Polyporaceae (13%), Irpicaceae (11%), Steraceae (7%), Meruliaceae (7%) and Phanerochaetaceae (7%) having the highest representation; the remaining 49% is made up of families that account for ≤5% of the total specimen amount (Figure 3).
Figure 2.
Division of isolated strains by Order rank.
Figure 3.
Division of isolated strains by Family rank.
3.2. Description and Growth Rate of Isolated Strains
The average growth rate (mm/day) of isolated strains calculated on three replicates is reported in Figure 4.
Figure 4.
Average growth rate of isolated strains in mm/day. The bar indicates the standard error.
The isolated strains growth rates ranged from 0.4 mm/day to a 13 mm/day. The highest growth rates were reported by: Merulius tremellosus (13 mm/day), Irpex lacteus (11.4 mm/day), Phlebia rufa (9.2 mm/day), Trametes versicolor (8.9 mm/day), Efibula tuberculata (8.6 mm/day), Stereum hirsutum (8.1 mm/day) and Porostereum spadiceum (8 mm/day). On the contrary, the lowest growth rates were reported by: Megalocystidium leucoxanthum (0.4 mm/day), Truncospora atlantica (0.4 mm/day), Xylodon nespori (0.5 mm/day), Botryobasidium asperulum (0.6 mm/day), Xenasmatella vaga (0.7 mm/day), Hericium erinaceus (0.7 mm/day) and Radulomyces molaris (0.7 mm/day).
The growth rate on standard culture media serves as basic information that characterises strains in a culture collection and is functional to the strain selection process for application research. Any industrial biotechnology (including fungal biotechnology) must rely on strains that quickly and consistently grow. Myco-materials and bio-composites, for example, require fast-growing strains capable of producing consistent mycelium and a predictable colour [37]. Analogously, myco-remediation applications heavily rely on enzymatic activity; thus, basic knowledge of the species ecology, trophism and degradation type in the wild serves for further research, such as the characterization of the enzymes they can produce and optimisation of secretion conditions. However, the growth rate of a specific species is insufficient information in and of itself, because various strains may exhibit different degradation and growth rates. Similarly, intraspecific morphological changes can be noticed in several strains, such as variable aerial mycelium development or colour pattern. As a result, each detained strain can display a different potential and should be identified and characterised.
All strains were subjected to morphological descriptions of colony morphology and microscopical characteristics. Table 3 contains a description of each strain. Photos of colonies were taken with the entire Petri dish covered; in the case of incomplete colonisation or slow growing strains, a deadline of 6 weeks following inoculation was established.
Table 3.
Microscopical characters, colony morphology and growth of isolated strains. Particularities or notable structures observed are reported in the “Notes” column. All of the photos are by Simone Buratti.
Most of the isolated strains had consistent colony morphology across the replicates and after transplantation. However, in other cases, the following cultural variables were observed:
- -
- The mycelium of Phlebiopsis crassa turned purple after a few weeks of growing in isolation, which is also a basidiomata feature. This characteristic was lost in subsequent cultures;
- -
- Hericium erinaceus exhibited two distinct morphologies: one that was more compact and consistently growing (as indicated in Table 3) and one with hyphae bundled to form aerial mycelium;
- -
- Truncospora atlantica colonies are characterized by powdery mycelium that can either cover the entire colony, making it entirely white, or cover it partially, resulting in a darker-coloured zonation.
The mycological literature abounds with descriptions of basidiomata morphology, whereas descriptions of mycelium in pure culture are sparse, if not missing.
To manage a new culture collection, each strain should be provided with a document containing information on the original field specimen, descriptions and photographic records. Cultural descriptions and photos are tools for comparing and checking the state of cultures and their morphology, as well as any changes and degeneration symptoms, during regular cultural procedures such as culture refreshing or transplantation [43,44]. Furthermore, such descriptions enable cross-validation of the response by molecular barcoding on pure cultures, as well as optimization of the barcoding effort itself.
It is noteworthy that approximately 25% of the species reported and described in this work still lack a description of their culture morphology. This reflects the general lack of knowledge about corticioid fungi, which is attributable to the highly specialized skills required for their identification. Because corticioids have often exiguous basidiomata and poor macromorphological traits, reference descriptions of isolates can boost confidence and provide an additional tool for proper identification and typification.
3.3. Notable Species in the New Strain Collection of Salamanca University: Issues and Potentiality
The new WDF strain collection of Salamanca University is a remarkable asset, since many corticioid species have, until now, been overlooked due to morphological cryptism and isolation difficulties. Even when several major culture collections in Europe (CBS, MUT, MUCL, LE-BIN/VKM) [45,46,47,48] are used as a reference, most corticioid species are only represented by a few strains, while others are completely absent. Compared to these references, this study isolated pure culture strains of Botryobasidium asperulum, Crustomyces subabruptus, Sertulicium granuliferum and Mycoacia gilvescens that were not present in other significant culture collections.
Although most of the strains currently held in the Salamanca University research culture collection are common species according to European florae, their conservation is crucial. According to the ex situ conservation principle, species that are common today may become rare and endangered in the future (declining population criterion). For instance, Grifola frondosa and Hericium erinaceus are fairly common species but are experiencing localised negative trends that are pushing them towards rarity. Grifola frondosa has been assigned the preliminary category of Least Concern (LC) at the global level and Near Threatened (NT) in Europe. This status was assigned because of population decline primarily due to habitat degradation. Similarly, Hericum erinaceus has been assigned Least Concern because it is still a common species in many countries, but is very rare in others. The population of this species is likewise declining due to habitat degradation [4]. Once more, it should be highlighted that most corticioid diversity is overlooked and therefore “data deficient” in terms of overall conservation status, habitat needs and population trends.
A summary of the most notable isolated species and the research opportunities available to them is listed below.
3.3.1. Species of Special Concern for Taxonomical and/or Biogeography Studies
Athelia epiphylla is considered a species complex and a challenging issue in taxonomy due to its very exiguous colonies and basidiomata, which are difficult to examine. This is why any novel strain in pure culture could be significant, especially when coupled with morphological description, because sclerotia are supposed to be discriminant traits. The specimen in this study was found growing on a basidiomata of H. rubiginosa and lacked any distinguishing feature from A. arachnoidea (i.e., bisporic basidia), although the latter is frequently lichenicolous [32].
Botryobasidium asperulum is a species distinguished by small ellipsoid and asperulate basidiospores. According to Langer [49], it is an eminently tropical species that was first reported in Cuba and subsequently collected throughout tropical areas of Africa (Guadeloupe, Gabon, Kenya, Malawi and Ethiopia). Botryobasidium stigmatisporum, as Boidin and Gilles reported from La Reunion, has ornamented basidiospores as well, although larger. The occurrence of B. asperulum in Europe is controversial; Bernicchia and Gorjón [31] reported several specimens from the Mediterranean region, but European specimens may belong to Botryobasidium laeve (J. Erikss.) Parmasto according to Larsson and Ryvarden [32]. The latter species is reported from North Europe and is distinguished by larger, smooth basidiospores; however, the same authors argued that ornamentations are tricky discriminants since they are often difficult to discern. The size and shape of the basidiospores of our specimen meet the concept of B. asperulum, and the asperulate ornamentation is visible.
So far, no B. asperulum sequences have been deposited in GenBank (NCBI) or other databases. The majority of the sequences deposited in the genus Botryobasidium are from the species B. laeve and B. subcoronatum. As a result, there are no B. asperulum comparative sequences: the ITS sequence obtained in this study may be the first for this species.
More sequences of this species, preferably from tropical zones, could help to enlarge the pool in databanks and enable appropriate molecular identification in order to resolve the distribution and taxonomy difficulties discussed above.
Phlebia rufa is a common and sub-cosmopolitan species, although it is most likely a species complex with several sibling entities. Consequently, there is a significant deal of interest in collecting cultures to assesss sexual compatibility as well as sequencing for phylogenetic studies. Basidiomata are generally resupinate or slightly reflexed and the gelatinous hymenophore is irregularly poroid to merulioid, cream to brown in color [31]. P. rufa generally produces large and massive basidiomata that spread to cover the whole substrate, which is typically a large trunk or fallen branch. It is a very efficient decomposer that occurs early in wood degradation and causes intense white rot, giving the wood a spongy and soft character. Due to its great degradation potential and high growth rate, it is a good candidate for biodegradation and bioremediation processes.
Phlebiopsis crassa is a holotropical species that has just been discovered in temperate Europe [50,51]. P. crassa was only previously known in Europe from a Polish antique collection [52], and it is now likely extinct at the collecting site [53]. This species’ reappearance in Southern Europe could be due to a recent import that has made it invasive or naturalised. P. crassa has violaceous, resupinate to reflexed basidiomata, as well as encrusted, brown cystidia and sometimes originates from the subiculum. It causes intense white rot that colonises small- and medium-sized branches in broadleaves. As a result, it is an excellent candidate for biodegradation procedures.
3.3.2. Species of Special Concern for Nutraceutical/Medicinal Properties
Grifola frondosa and Hericium erinaceus are becoming increasingly scarce in the wild [4] and are widely known for their therapeutic potential. Grifola frondosa is a well-known edible fungus not only for its high nutritional content and flavor, but also for its bioactive properties and application in therapeutic goods [54]. Hericium erinaceus is a renowned medicinal mushroom that has been studied for the treatment of neurodegenerative diseases as well as for its metabolites, bioactive compounds and numerous nutraceutical properties such as anticancer, antioxidant, antimicrobial, neuroprotective, immunomodulatory and anti-aging [55,56,57].
Pleurotus eryngii frequently interacts with Apiaceae roots, including Eryngium spp. In this study, a strain of Pleurotus eryngii var. ferulae was isolated from the roots of Ferula communis L. The variant ferulae is a popular edible fungus due to the huge size of its basidiomata and the nutraceutical benefits of its metabolites [58]. A strain of Pleurotus pulmonarius was also isolated; while being less popular than other Pleurotus species such as P. ostreatus, this species is important for its edible and therapeutic characteristics [57,59,60]. Finally, Pleurotus species have also been proposed for the biodegradation of pollutants and recalcitrant substrates such as polycyclic aromatic hydrocarbons [61], crude oil [62], bisphenol A [63] and phenolic compounds in olive oil wastewater [64].
3.3.3. Species of Special Concern for Enzymatic and/or Degradation Potential
Irpex lacteus is a white rot agent with significant biotechnological potential for water and soil bioremediation [65,66]. I. lacteus eso-enzymes have been shown to digest polycyclic aromatic tri- to hexa-cyclic hydrocarbons [67], TNT [68], synthetic dyes [69,70] and a variety of other contaminants [65,66]. The strain isolated in this study grew at the second fastest rate, demonstrating its usefulness for biomass production.
Phanerochaete sordida is a common and widespread species in Europe, where it is found on the decaying wood of deciduous trees, rarely conifers. Because of its wide distribution, it is a highly polymorphic species [71]. Phanerochaete sordida and Phanerochaete chrysosporium are two of the most investigated species for pollutant degradation due to their high enzymatic efficiency and fast growth. Although P. sordida has received less attention than P. chrysosporium, it has been reported to degrade pollutants such as polycyclic aromatic hydrocarbons [72], neonicotinoid insecticides [73] and pharmaceuticals [74]. This is significant since P. sordida strains can be gathered from temperate, boreal regions, unlike P. chrysosporium.
Three common Stereum species were isolated: Stereum hirsutum, Stereum gausapatum and Stereum subtomentosum. Because they produce aggressive white rot, they are all recognised as pioneers in the early stages of wood degradation. Stereum hirsutum is the most common species, with a seemingly cosmopolitan distribution and high growth rate. Because of these factors, it may be a suitable option for myco-material technologies [37]. Furthermore, Goppa et al. [75] identified S. hirsutum as a possible novel food based on a range of compounds discovered in the mycelium, including a high choline content. According to Jovic et al. [76], S. gausapatum strains can produce an array of enzymes including laccases, manganese-dependent peroxidases, multifunctional peroxidases and lignin peroxidases. Because of the potential for biodegradation, this makes S. gausapatum a species of particular interest. Both the strains of S. gausapatum and S. hirsutum obtained in this work grew faster than the average.
Trametes versicolor is one of the most widely utilized fungal species due to its degradative properties and enzymes, as well as its ability to produce several metabolites, including medicinal ones [57,77]. It is currently regarded as a cosmopolitan species, although it is a highly variable and possibly complex species difficult to discriminate [78]. It has a high degradative capacity, causing branches and trunks to break down during the early stages of wood degradation. The isolation of various strains could aid in the further taxonomical and physiological (e.g., enzymatic) characterization of this species.
Trichaptum abietinum is a pioneer species that produces small basidiomata on newly fallen Picea and Abies logs and stumps. It is a fast-growing saprotroph that degrades the sapwood of dead hosts, causing white pocket rot. On the other hand, Trichaptum biforme also colonizes the earlier wood stages but is associated with hardwoods. Trichaptum biforme displays laccase and peroxidase activity and can decolorize several aromatic dyes, implying that it has good bioremediation potential [79,80,81,82].
4. Conclusions
Culture collections, in addition to their fundamental role of conserving fungal material ex situ, allow for the sharing, exchange and application of strains for knowledge and scientific research.
The newly established strain collection of Salamanca University contributes to the ex situ conservation of Mediterranean WDF. The new fungal strains culture collection of Salamanca University contains 55 strains of WDF (corticioid, polyporoid and a few agarics) from 50 different species, 25% of which have never been described in pure culture before. The collection also includes four strains belonging to species not found in other major European collections: Botryobasidium asperulum, Crustomyces subabruptus, Sertulicium granuliferum and Mycoacia gilvescens.
These strains represent a subset of Mediterranean fungal diversity and provide a solid basis for future pure and applied research.
Several strains in the collection could be used for taxonomic and species distribution research, as well as applied mycology.
Botryobasidium asperulum and P. rufa need further research: the former to solve the controversies about its presence in Europe, the latter to disentangle its species complex and its phylogenetics. Botryobasidium asperulum is likewise interesting because of the complete lack of DNA sequences in databases. The medicinal properties of Hericium erinaceus, G. frondosa, P. eryngii and P. pulmonarius, as well as the increasing number of new bioactive compounds discovered, make these species stand out. Many of the isolated species, such as I. lacteus, P. sordida and T. versicolor, have a broad applicative spectrum. Finally, the fast growth and/or enzymatic potential of S. gausapatum and S. hirsutum make them promising candidates for degradation and bioremediation applications.
Future research goals also include exploring further methods to preserve the viability and full physiological functionality of the strains, e.g., by growing them on suitable lignocellulosic substrates in axenic conditions.
Author Contributions
Conceptualization, S.B., S.P.G., C.E.G. and E.S.; methodology, S.B. and S.P.G.; validation, S.P.G., C.E.G. and E.S.; formal analysis, S.B.; investigation, S.B. and S.P.G.; resources, S.P.G. and E.S.; writing—original draft preparation, S.B. and S.P.G.; writing—review and editing, S.B., S.P.G., C.E.G. and E.S.; visualization, S.B.; supervision, S.P.G. and E.S.; project administration, S.P.G. and E.S.; funding acquisition, E.S. All authors have read and agreed to the published version of the manuscript.
Funding
This research was funded by Regione Lombardia, POR FESR 2014–2020—Call HUB Ricerca e Innovazione, Progetto 1139857 CE4WE: Approvvigionamento energetico e gestione della risorsa idrica nell’ottica dell’Economia Circolare (Circular Economy for Water and Energy) and by Erasmus+ traineeship grant.
Data Availability Statement
The data presented in this study are contained within the article.
Acknowledgments
Teresa Malvar (University of Salamanca Plant DNA Biobank) is acknowledged for technical support in molecular work and Francisco Javier Hernández (University of Salamanca SALA Herbarium) for technical assistance. The authors are grateful to Rebecca Michela Baiguera for her contribution to the present work during her research activity at the Mycology Laboratory of the Dep. Earth and Environmental Sciences of the University of Pavia (Italy).
Conflicts of Interest
The authors declare no conflict of interest.
References
- The IUCN Red List of Threatened Species. Available online: https://www.iucnredlist.org/ (accessed on 4 October 2023).
- Hawksworth, D.L.; Lücking, R. Fungal diversity revisited: 2.2 to 3.8 million species. Microbiol. Spectr. 2017, 5, 10–1128. [Google Scholar] [CrossRef] [PubMed]
- Dahlberg, A.; Mueller, G.M. Applying IUCN red-listing criteria for assessing and reporting on the conservation status of fungal species. Fungal Ecol. 2011, 4, 147–162. [Google Scholar] [CrossRef]
- The Global Fungal Red List Initiative. Available online: https://redlist.info/en/iucn/welcome (accessed on 12 July 2023).
- Mueller, G.M.; Cunha, K.M.; May, T.W.; Allen, J.L.; Westrip, J.R.S.; Canteiro, C.; Costa-Rezende, D.H.; Drechsler-Santos, E.R.; Vasco-Palacios, A.M.; Ainsworth, A.M.; et al. What Do the First 597 Global Fungal Red List Assessments Tell Us about the Threat Status of Fungi? Diversity 2022, 14, 736. [Google Scholar] [CrossRef]
- Ellis, C.J.; Asplund, J.; Benesperi, R.; Branquinho, C.; Di Nuzzo, L.; Hurtado, P.; Martínez, I.; Matos, P.; Nascimbene, J.; Pinho, P.; et al. Functional Traits in Lichen Ecology: A Review of Challenge and Opportunity. Microorganisms 2021, 9, 766. [Google Scholar] [CrossRef]
- Dighton, J.; Sridhar, K.R.; Deshmukh, S.K. The Roles of Macro Fungi (Basidomycotina) in Terrestrial Ecosystems. In Advances in Macrofungi: Diversity, Ecology and Biotechnology; CRC-Press: Boca Raton, FL, USA, 2019; pp. 70–104. [Google Scholar]
- Heilmann-Clausen, J.; Barron, E.S.; Boddy, L.; Dahlberg, A.; Griffith, G.W.; Nordén, J.; Ovaskainen, O.; Perini, C.; Senn-Irlet, B.; Halme, P. A fungal perspective on conservation biology. Conserv. Biol. 2015, 29, 61–68. [Google Scholar] [CrossRef]
- Rosso, M.N.; Berrin, J.G.; Lomascolo, A. Plant Wastes and Sustainable Refineries: What Can We Learn from Fungi? Curr. Opin. Green Sustain. Chem. 2022, 34, 100602. [Google Scholar] [CrossRef]
- Selbmann, L.; Egidi, E.; Isola, D.; Onofri, S.; Zucconi, L.; de Hoog, G.S.; Chinaglia, S.; Testa, L.; Tosi, S.; Balestrazzi, A.; et al. Biodiversity, Evolution and Adaptation of Fungi in Extreme Environments. Plant Biosyst.—Int. J. Deal. All Asp. Plant Biol. 2013, 147, 237–246. [Google Scholar] [CrossRef]
- Nagy, L.G.; Riley, R.; Bergmann, P.J.; Krizsán, K.; Martin, F.M.; Grigoriev, I.V.; Cullen, D.; Hibbett, D.S. Genetic Bases of Fungal White Rot Wood Decay Predicted by Phylogenomic Analysis of Correlated Gene-Phenotype Evolution. Mol. Biol. Evol. 2017, 34, 35–44. [Google Scholar] [CrossRef]
- Krah, F.S.; Bässler, C.; Heibl, C.; Soghigian, J.; Schaefer, H.; Hibbett, D.S. Evolutionary Dynamics of Host Specialization in Wood-Decay Fungi. BMC Evol. Biol. 2018, 18, 119. [Google Scholar] [CrossRef]
- Hyde, K.D.; Xu, J.; Rapior, S.; Jeewon, R.; Lumyong, S.; Niego, A.G.T.; Abeywickrama, P.D.; Aluthmuhandiram, J.V.S.; Brahamanage, R.S.; Brooks, S.; et al. The amazing potential of fungi: 50 ways we can exploit fungi industrially. Fungal Divers. 2019, 97, 1–136. [Google Scholar] [CrossRef]
- Cerimi, K.; Akkaya, K.C.; Pohl, C.; Schmidt, B.; Neubauer, P. Fungi as Source for New Bio-Based Materials: A Patent Review. Fungal Biol. Biotechnol. 2019, 6, 17. [Google Scholar] [CrossRef] [PubMed]
- Almpani-Lekka, D.; Pfeiffer, S.; Schmidts, C.; Seo, S. A Review on Architecture with Fungal Biomaterials: The Desired and the Feasible. Fungal Biol. Biotechnol. 2021, 8, 17. [Google Scholar] [CrossRef] [PubMed]
- Zhuo, R.; Fan, F. A Comprehensive Insight into the Application of White Rot Fungi and Their Lignocellulolytic Enzymes in the Removal of Organic Pollutants. Sci. Total Environ. 2021, 778, 146132. [Google Scholar] [CrossRef] [PubMed]
- WFCC—World Federation for Culture Collections. Available online: https://wfcc.info/guideline (accessed on 29 June 2023).
- Sette, L.D.; Pagnocca, F.C.; Rodrigues, A. Microbial Culture Collections as Pillars for Promoting Fungal Diversity, Conservation and Exploitation. Fungal Genet. Biol. 2013, 60, 2–8. [Google Scholar] [CrossRef] [PubMed]
- De Vero, L.; Boniotti, M.B.; Budroni, M.; Buzzini, P.; Cassanelli, S.; Comunian, R.; Gullo, M.; Logrieco, A.F.; Mannazzu, I.; Musumeci, R.; et al. Preservation, Characterization and Exploitation of Microbial Biodiversity: The Perspective of the Italian Network of Culture Collections. Microorganisms 2019, 7, 685. [Google Scholar] [CrossRef] [PubMed]
- World Federation for Culture Collections: Guidelines for the Establishment and Operation of Collections of Cultures of Microorganisms, 3rd Edition, February 2010. Available online: https://wfcc.info/home_view (accessed on 2 September 2023).
- Santos, I.M.; Lima, N. Criteria Followed in the Establishment of a Filamentous Fungal Culture Collection—Micoteca Da Universidade Do Minho (MUM). World J. Microbiol. Biotechnol. 2001, 17, 215–220. [Google Scholar] [CrossRef]
- The Microbial Resource Research Infrastructure (MIRRI). Available online: https://www.mirri.org/ (accessed on 4 October 2023).
- Becker, P.T.; Stubbe, D.; Claessens, J.; Roesems, S.; Bastin, Y.; Planard, C.; Cassagne, C.; Piarroux, R.; Hendrickx, M. Quality control in culture collections: Confirming identity of filamentous fungi by MALDI-TOF MS. Mycoscience 2014, 56, 273–279. [Google Scholar] [CrossRef]
- Cartabia, M.; Girometta, C.E.; Baiguera, R.M.; Buratti, S.; Babbini, S.; Bernicchia, A.; Savino, E. Lignicolous fungi collected in northern Italy: Identification and morphological description of isolates. Diversity 2022, 14, 413. [Google Scholar] [CrossRef]
- Girometta, C.E.; Bernicchia, A.; Baiguera, R.M.; Bracco, F.; Buratti, S.; Cartabia, M.; Picco, A.M.; Savino, E. An Italian Research Culture Collection of Wood Decay Fungi. Diversity 2020, 12, 58. [Google Scholar] [CrossRef]
- Climate Data. Available online: https://it.climate-data.org/europa/spagna/ (accessed on 13 July 2023).
- Gams, W.; Van der Aa, H.A.; Van der Plaats-Niterink, A.J.; Samson, R.A.; Stalpers, J.A. CBS Course of Mycology (No. Ed. 3). Centraalbureau voor Schimmelcultures (CBS); Westerdjik: Utrecht, The Netherlands, 1997. [Google Scholar]
- Hakala, T.K.; Maijala, P.; Konn, J.; Hatakka, A. Evaluation of novel wood-rotting polypores and corticioid fungi for the decay and biopulping of Norway spruce (Picea abies) wood. Enzym. Microb. Technol. 2004, 34, 255–263. [Google Scholar] [CrossRef]
- Bernicchia, A.; Gorjón, S.P. Polypores of the Mediterranean Region; Romar: Segrate, Italy, 2020. [Google Scholar]
- Choi, Y.W.; Hyde, K.D.; Ho, W.H. Single spore isolation of fungi. Fungal Divers. 1999, 3, 29–38. [Google Scholar]
- Bernicchia, A.; Gorjón, S.P. Corticiaceae sl.; Fungi Europaei 12; Candusso: Alassio, Italy, 2010. [Google Scholar]
- Larsson, K.H.; Ryvarden, L. Corticioid Fungi of Europe: Acanthobasidium-Gyrodontium; Fungiflora: Oslo, Norway, 2021. [Google Scholar]
- NCBI. Available online: https://blast.ncbi.nlm.nih.gov (accessed on 1 June 2023).
- Mycobank. Available online: www.mycobank.org (accessed on 1 June 2023).
- Nobles, M.K. Identification of cultures of wood-inhabiting Hymenomycetes. Can. J. Bot. 1965, 43, 1097–1139. [Google Scholar] [CrossRef]
- Stalpers, J.A. Identification of wood-inhabiting fungi in pure culture. Stud. Mycol. 1978, 16, 1–248. [Google Scholar]
- Cartabia, M.; Girometta, C.E.; Milanese, C.; Baiguera, R.M.; Buratti, S.; Branciforti, D.S.; Vadivel, D.; Girella, A.; Babbini, S.; Savino, E.; et al. Collection and Characterization of Wood Decay Fungal Strains for Developing Pure Mycelium Mats. J. Fungi 2021, 7, 1008. [Google Scholar] [CrossRef] [PubMed]
- Petre, C.V.; Tanase, C. Culture characteristics of 20 lignicolous basidiomycetes species that synthesize volatile organic compounds. Analele Stiintifice ale Universitatii" Al. I. Cuza" din Iasi 2013, 59, 37. [Google Scholar]
- Balaeş, T.; Tănase, C. Culture description of some spontaneous lignicolous macromycetes species. J. Plant Dev. 2012, 19, 83–97. [Google Scholar]
- Nakasone, K.K. Cultural and morphological studies of Gloeocystidiellum porosum and Gloeocystidium clavuligerum. Mycotaxon 1982, 14, 316–324. [Google Scholar]
- Nagadesi, P.K.; Arya, A.; Babu, D.N.; Prasad, K.S.M.; Devi, P.P. Identification of volatile organic compound producing Lignicolous fungal cultures from Gujarat, India. World Sci. News 2017, 90, 150–165. [Google Scholar]
- Bakshi, B.K.; Sehgal, H.S.; Singh, B. Cultural diagnosis of Indian Polyporaceae. I. Genus Polyporus. Indian For. Rec. 1969, 2, 205–244. [Google Scholar]
- Xiong, C.; Xia, Y.; Zheng, P.; Wang, C. Increasing oxidative stress tolerance and subculturing stability of Cordyceps militaris by overexpression of a glutathione peroxidase gene. Appl. Microbiol. Biotechnol. 2013, 97, 2009–2015. [Google Scholar] [CrossRef]
- Pérez, G.; Lopez-Moya, F.; Chuina, E.; Ibañez-Vea, M.; Garde, E.; López-Llorca, L.V.; Pisabarro, A.G.; Ramírez, L. Strain degeneration in Pleurotus ostreatus: A genotype dependent oxidative stress process which triggers oxidative stress, cellular detoxifying and cell wall reshaping genes. J. Fungi 2021, 7, 862. [Google Scholar] [CrossRef] [PubMed]
- CBS-KNAW Collections—Westerdijk Institute. Available online: https://wi.knaw.nl/Collection (accessed on 12 July 2023).
- Mut-Mycotheca Universitatis Taurinensis. Available online: https://www.tucc-database.unito.it/mut (accessed on 12 July 2023).
- BCCM/MUCL Agro-Food & Environmental Fungal Collection. Available online: https://bccm.belspo.be/about-us/bccm-mucl (accessed on 12 July 2023).
- LE-BIN Strains—All-Russian Collection of Microorganisms—VKM. Available online: http://www.vkm.ru/eCatalogue/LE-BIN.htm (accessed on 12 July 2023).
- Langer, G. Die gattung Botryobasidium Donk (Corticiaceae, Basidiomycetes). Bibl. Mycol. 1994, 158, 459. [Google Scholar]
- Salcedo, I.; Olariaga, I. Phanerochaete crassa (Lév.) Burds., nueva cita para la micoflora de la Península Ibérica. Rev. Catalana Micol. 2008, 30, 93–99. [Google Scholar]
- Gorjón, S.P.; Hallenberg, N.; Bernicchia, A. A survey of the corticioid fungi from the Biosphere Reserve of Las Batuecas-Sierra de Francia (Spain). Mycotaxon 2009, 109, 161–164. [Google Scholar] [CrossRef]
- Bresadola, G. Fungi Polonici a el. Viro B. Eichler lecti. Ann. Mycol. 1903, 1, 65–131. [Google Scholar]
- Snowarski, M. Mushrooms and Fungi of Poland. Polish Red List of Macrofungi. 2006. Available online: http://www.grzyby.pl/czerwonalista-Aphyllophorales.htm (accessed on 20 July 2023).
- Wu, J.Y.; Siu, K.C.; Geng, P. Bioactive Ingredients and Medicinal Values of Grifola frondosa (Maitake). Foods 2021, 10, 95. [Google Scholar] [CrossRef]
- Ghosh, S.; Nandi, S.; Banerjee, A.; Sarkar, S.; Chakraborty, N.; Acharya, K. Prospecting medicinal properties of Lion’s mane mushroom. J. Food Biochem. 2021, 45, e13833. [Google Scholar] [CrossRef]
- Jiang, S.; Wang, S.; Sun, Y.; Zhang, Q. Medicinal properties of Hericium erinaceus and its potential to formulate novel mushroom-based pharmaceuticals. Appl. Microbiol. Biotechnol. 2014, 98, 7661–7670. [Google Scholar] [CrossRef]
- Venturella, G.; Ferraro, V.; Cirlincione, F.; Gargano, M.L. Medicinal mushrooms: Bioactive compounds, use, and clinical trials. Int. J. Mol. Sci. 2021, 22, 634. [Google Scholar] [CrossRef]
- Flores, G.A.; Girometta, C.E.; Cusumano, G.; Pellegrino, R.M.; Silviani, S.; Bistocchi, G.; Arcangeli, A.; Ianni, F.; Blasi, F.; Cossignani, L.; et al. Diversity of Pleurotus spp. (Agaricomycetes) and Their Metabolites of Nutraceutical and Therapeutic Importance. Int. J. Med. Mushrooms 2023, 25, 1–20. [Google Scholar] [CrossRef]
- Patel, Y.; Narian, R.; Singh, V.K. Medicinal properties of Pleurotus species (Oyster Mushroom): A Review. World J. Fungal Plant Biol. 2012, 3, 1–12. [Google Scholar]
- Stastny, J.; Marsik, P.; Tauchen, J.; Bozik, M.; Mascellani, A.; Havlik, J.; Landa, P.; Jablonsky, I.; Treml, J.; Herczogova, P.; et al. Antioxidant and Anti-Inflammatory Activity of Five Medicinal Mushrooms of the Genus Pleurotus. Antioxidants 2022, 11, 1569. [Google Scholar] [CrossRef] [PubMed]
- Bezalel, L.; Hadar, Y.; Cerniglia, C.E. Mineralization of polycyclic aromatic hydrocarbons by the white rot fungus Pleurotus ostreatus. Appl. Environ. Microbiol. 1996, 62, 292–295. [Google Scholar] [CrossRef] [PubMed]
- Pozdnyakova, N.N.; Nikitina, V.E.; Turovskaya, O.V. Bioremediation of oil-polluted soil with an association including the fungus Pleurotus ostreatus and soil microflora. Appl. Biochem. Microbiol. 2008, 44, 60–65. [Google Scholar] [CrossRef]
- Hirano, T.; Honda, Y.; Watanabe, T.; Kuwahara, M. Degradation of bisphenol A by the lignin-degrading enzyme, manganese peroxidase, produced by the white-rot basidiomycete, Pleurotus ostreatus. Biosci. Biotechnol. Biochem. 2000, 64, 1958–1962. [Google Scholar] [CrossRef] [PubMed]
- Aggelis, G.; Iconomou, D.; Christou, M.; Bokas, D.; Kotzailias, S.; Christou, G.; Tsagou, V.; Papanikolaou, S. Phenolic removal in a model olive oil mill wastewater using Pleurotus ostreatus in bioreactor cultures and biological evaluation of the process. Water Res. 2003, 37, 3897–3904. [Google Scholar] [CrossRef]
- Novotny, C.; Cajthaml, T.; Svobodova, K.; Susla, M.; Sasek, V. Irpex lacteus, a white-rot fungus with biotechnological potential—review. Folia Microbiol. 2009, 54, 375–390. [Google Scholar] [CrossRef]
- Novotny, C.; Erbanova, P.; Cajthaml, T.; Rothschild, N.; Dosoretz, C.; Sasek, V. Irpex lacteus, a white rot fungus applicable to water and soil bioremediation. Appl. Microbiol. Biotechnol. 2000, 54, 850–853. [Google Scholar] [CrossRef]
- Cajthaml, T.; Erbanová, P.; Kollmann, A.; Novotný, Č.; Šašek, V.; Mougin, C. Degradation of PAHs by ligninolytic enzymes of Irpex lacteus. Folia Microbiol. 2008, 53, 289–294. [Google Scholar] [CrossRef]
- Kim, H.Y.; Song, H.G. Transformation and mineralization of 2, 4, 6-trinitrotoluene by the white rot fungus Irpex lacteus. Appl. Microbiol. Biotechnol. 2003, 61, 150–156. [Google Scholar] [CrossRef]
- Shin, K.; Kim, Y.H.; Lim, J. Purification and characterization of manganese peroxidase of the white-rot fungus Irpex lacteus. J. Microbiol. Seoul 2005, 43, 503. [Google Scholar]
- Svobodová, K.; Majcherczyk, A.; Novotn, C.; Kües, U. Implication of mycelium associated laccase from Irpex lacteus in the decolorization of synthetic dyes. Bioresour. Technol. 2008, 99, 463–471. [Google Scholar] [CrossRef] [PubMed]
- Eriksson, J.; Hjortstam, K.; Ryvarden, L. The Corticiaceae of North Europe Vol. 5; Fungiflora: Oslo, Norway, 1979. [Google Scholar]
- Li, Q.; Wang, J.; Wang, Z.; Zhang, W.; Zhan, H.; Xiao, T.; Yu, X.; Zheng, Y. Surfactants Double the Biodegradation Rate of Persistent Polycyclic Aromatic Hydrocarbons (PAHs) by a White-Rot Fungus Phanerochaete sordida. Environ. Earth Sci. 2023, 82, 285. [Google Scholar] [CrossRef]
- Wang, J.; Tanaka, Y.; Ohno, H.; Jia, J.; Mori, T.; Xiao, T.; Yan, B.; Kawagishi, H.; Hirai, H. Biotransformation and Detoxification of the Neonicotinoid Insecticides Nitenpyram and Dinotefuran by Phanerochaete sordida YK-624. Environ. Pollut. 2019, 252, 856–862. [Google Scholar] [CrossRef] [PubMed]
- Rastogi, A.; Tiwari, M.K.; Ghangrekar, M.M. A Review on Environmental Occurrence, Toxicity and Microbial Degradation of Non-Steroidal Anti-Inflammatory Drugs (NSAIDs). J. Environ. Manag. 2021, 300, 113694. [Google Scholar] [CrossRef] [PubMed]
- Goppa, L.; Spano, M.; Baiguera, R.M.; Cartabia, M.; Rossi, P.; Mannina, L.; Savino, E. NMR-Based Characterization of Wood Decay Fungi as Promising Novel Foods: Abortiporus biennis, Fomitopsis iberica and Stereum hirsutum Mycelia as Case Studies. Foods 2023, 12, 2507. [Google Scholar] [CrossRef] [PubMed]
- Jović, J.; Buntić, A.; Radovanović, N.; Petrović, B.; Mojović, L. Lignin-degrading abilities of novel autochthonous fungal isolates Trametes hirsuta F13 and Stereum gausapatum F28. Food Technol. Biotechnol. 2018, 56, 354. [Google Scholar] [CrossRef]
- Tišma, M.; Žnidaršič-Plazl, P.; Šelo, G.; Tolj, I.; Šperanda, M.; Bucić-Kojić, A.; Planinić, M. Trametes versicolor in Lignocellulose-Based Bioeconomy: State of the Art, Challenges and Opportunities. Bioresour. Technol. 2021, 330, 124997. [Google Scholar] [CrossRef]
- Carlson, A.; Justo, A.; Hibbett, D.S. Species Delimitation in Trametes: A Comparison of ITS, RPB1, RPB2 and TEF1 Gene Phylogenies. Mycologia 2014, 106, 735–745. [Google Scholar] [CrossRef]
- Elisashvili, V.; Kachlishvili, E.; Tsiklauri, N.; Metreveli, E.; Khardziani, T.; Agathos, S.N. Lignocellulose-degrading enzyme production by white-rot basidiomycetes isolated from the forests of Georgia. World J. Microbiol. Biotechnol. 2008, 25, 331–339. [Google Scholar] [CrossRef]
- Okino, L.K.; Machado, K.M.G.; Fabris, C.; Bononi, V.L.R. Ligninolytic activity of tropical rainforest basidiomycetes. World J. Microbiol. Biotechnol. 2000, 16, 889–893. [Google Scholar] [CrossRef]
- Eshghi, H.; Alishahi, Z.; Zokaei, M.; Daroodi, A.; Tabasi, E. Decolorization of methylene blue by new fungus: Trichaptum biforme and decolorization of three synthetic dyes by Trametes hirsuta and Trametes gibbosa. Eur. J. Chem. 2011, 2, 463–468. [Google Scholar] [CrossRef]
- Freitag, M.; Morrell, J.J. Decolorization of the polymeric dye Poly R-478 by wood-inhabiting fungi. Can. J. Microbiol. 1992, 38, 811–822. [Google Scholar] [CrossRef]
Disclaimer/Publisher’s Note: The statements, opinions and data contained in all publications are solely those of the individual author(s) and contributor(s) and not of MDPI and/or the editor(s). MDPI and/or the editor(s) disclaim responsibility for any injury to people or property resulting from any ideas, methods, instructions or products referred to in the content. |
© 2023 by the authors. Licensee MDPI, Basel, Switzerland. This article is an open access article distributed under the terms and conditions of the Creative Commons Attribution (CC BY) license (https://creativecommons.org/licenses/by/4.0/).